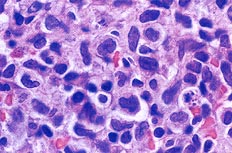

症例 49
| 年齢 | 50歳代 | |||
|---|---|---|---|---|
| 現病歴 | 全身リンパ節腫脹を近医にて指摘され、血液検査にて白血球が増加していたため、精査のため入院となる. | |||
| 血液学所見 | WBC(/μL) | 236,920 | RBC(万/μL) | 473 |
| Hb(g/dL) | 11.0 | Ht(%) | 42.1 | |
| PLT(万/μL) | 7.2 | MCV(fL) | 89.0 | |
| MCH(pg) | 23.2 | MCHC(%) | 26.1 | |
| 血液像(%) | Ab.Ly | 83.0 | ||
| 骨髄所見 | NCC(万/μL) | 48.7 | Ly様 | 15.0 |
| Blast(%) | Ab.Ly | 52.0 | ||
| 生化学所見 | LDH 702 U/L, Ca 14.5 mg/dL, UA 10.4 mg/dL | |||
![]() |
![]() |
|
|---|---|---|
| [骨髄×400.MG染色] N/C比が高く、比較的小型な細胞がみられる. 周囲には核影もみられる. |
[骨髄×1000.MG染色] 小型細胞は濃染性で核形不整がみられる. |
|
![]() |
![]() |
|
| [骨髄×1000.MG染色] 核形不整は顕著で多様性である. |
[骨髄×1000.PO染色] 小型細胞はPO染色,PAS染色に陰性である. |
|
![]() |
||
| [リンパ節生検×400.HE染色] 大小不同性でクロマチンは粗網状で核形不整が顕著である. (久留米大学病理部 大島孝一先生によりご提供されたもの) |
||
| 下記の中から答えをお選びください。 | |
| 1 | リンパ形質細胞性腫瘍(LPL) |
|---|---|
| 2 | ヘアリー細胞白血病(HCL) |
| 3 | バーキット白血病(BL) |
| 4 | 前リンパ球性白血病(PLL) |
| 5 | 成人T細胞白血病/リンパ腫(ATLL) |